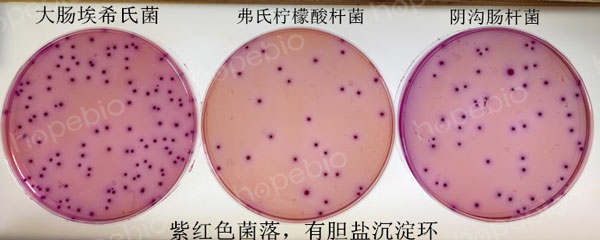
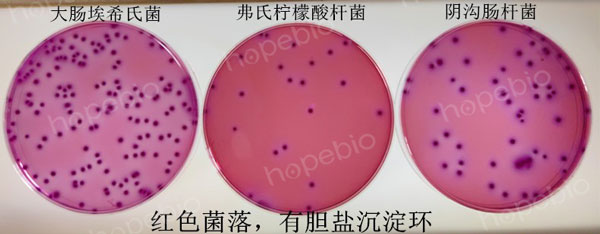

海博微信公众号
海博微信公众号
 海博天猫旗舰店
海博天猫旗舰店


 海博微信公众号
海博微信公众号
 海博天猫旗舰店
海博天猫旗舰店




一、简介
在实际工作中,经常有人将VRBA和VRBGA混淆,甚至有人认为两者是一种培养基,在购买、使用过程中造成错误。本文主要对这两种培养基的使用和原理等方面做出详细说明,并对相关问题进行探讨。
二、比较
两种培养基的异同情况如表1。
表1 VRBA和VRBGA的比较表
|
比较项目 |
VRBA |
VRBGA |
|
|
中文名字 |
结晶紫中性红胆盐琼脂 |
结晶紫中性红胆盐葡萄糖琼脂 |
|
|
英文 |
Violet Red Bile Agar |
Violet Red Bile Glucose Agar |
|
|
货号 |
HB0114 |
HB0176-4 |
|
|
用途 |
用于大肠菌群的固体平板检测 |
用于肠杆菌科的分离培养 |
|
|
成分 (g/L) |
酵母浸粉 3.0 蛋白胨 7.0 氯化钠 5.0 乳糖 10.0 3号胆盐 1.5 结晶紫 0.002 中性红 0.03 琼脂 15.0 pH值7.4±0.1 25℃ |
酵母浸粉 3.0 蛋白胨 7.0 氯化钠 5.0 葡萄糖 10.0 3号胆盐 1.5 结晶紫 0.002 中性红 0.03 琼脂 12.0 pH值7.4±0.2 25℃ |
|
|
成分区别 |
乳糖 |
葡萄糖 |
|
|
原理 |
同 |
蛋白胨提供氮源,碳源,维生素和矿物质;酵母浸粉能够提供微生物生长特别需要的B族维生素;氯化钠可维持均衡的渗透压;胆盐和结晶紫能抑制样品中的革兰氏阳性菌;中性红为指示剂;琼脂是培养基的凝固剂。 |
|
|
异 |
乳糖为唯一发酵底物 |
葡萄糖为唯一发酵底物 |
|
|
培养条件 |
36℃±1℃培养18h~24h |
||
|
质 控 菌 株 特 征 |
大肠 埃希 氏菌 |
紫红色菌落,可有胆盐沉淀环 |
红色菌落,有胆盐沉淀环 |
|
弗氏 柠檬 酸杆 菌 |
紫红色菌落,可有胆盐沉淀环 |
红色菌落,有胆盐沉淀环 |
|
|
阴沟肠杆菌 |
紫红色菌落,可有胆盐沉淀环 |
红色菌落,有胆盐沉淀环 |
|
|
鼠伤 寒沙 门氏 菌 |
红色菌落,无胆盐沉淀环 |
红色菌落,有胆盐沉淀环 |
|
|
福氏 志贺 氏菌 |
红色菌落,无胆盐沉淀环 |
红色菌落,有胆盐沉淀环 |
|
通过比较,我们可以看到两种培养基的主要成分几乎一模一样:蛋白胨提供氮源、碳源、维生素和矿物质;酵母浸粉提供微生物生长特别需要的B族维生素;胆盐和结晶紫能抑制样品中的革兰氏阳性菌;中性红为指示剂;琼脂是凝固剂。
两者的区别在于糖类底物的差异:VRBA的底物是乳糖,而VRBGA的底物是葡萄糖。质控菌菌落特征有差别:不同的菌用两种培养基倾注培养,形成的菌落特征会有差异(如表1、图1、图2)。
三、讨论
通过上面的比较,可以看出这是两款不同用途的培养基,为了更好地理解这两款培养基,首先要弄清“大肠菌群”和“肠杆菌科”这两个概念。
有关大肠菌群,《GB 4789.3-2016 食品安全国家标准食品微生物学检验大肠菌群计数》中将其定义为“在一定培养条件下能发酵乳糖、产酸产气的需氧和兼性厌氧革兰氏阴性无芽胞杆菌”。“大肠菌群”并不是一个细菌分类学概念,也就是说,在正规分类学谱系中,是找不到“大肠菌群”这个定义的,普遍定义的大肠菌群通常包括以下几个属:肠杆菌属(Enterobacter)、柠檬酸菌属(Citrobacter)、埃希氏菌属(Escherichia)、克雷伯氏菌数(Klebsiella)、哈夫尼亚菌属(Hafnia)。
有关肠杆菌科,《GB 4789.3-2016 食品安全国家标准食品微生物学检验肠杆菌科检验》中是这样定义的,“在给定条件下发酵葡萄糖产酸、氧化酶阴性的需氧或兼性厌氧革兰氏阴性无芽胞杆菌”。肠肝菌科(Enterobacteriaceae family)是严格的细菌分类学定义,包括克罗诺菌属(Cronobacter)、沙门氏菌属(Salmonella)、肠杆菌属(Enterobacter)、柠檬酸菌属(Citrobacter)、埃希氏菌属(Escherichia)、志贺菌属(Shigella)等等。
肠杆菌科与大肠菌群最大的区别在于,它不能在37°C下发酵乳糖,进而产酸或产气。因此,像沙门氏、志贺菌、变形杆菌等这些肠杆菌科中最重要的若干门类都被排除在大肠菌群集群以外。
正是因为上面所述的原因,VRBA(结晶紫中性红胆盐琼脂)内含乳糖作为唯一糖类底物,专门用于检测大肠菌群。典型大肠菌群细菌在VRBA上呈现紫红色菌落,有时带胆盐沉淀环。非大肠菌群如沙门氏菌属的菌落呈现红色,无胆盐沉淀环(如图1)。当待测产品中本身含有乳糖以外的糖类时,这些糖类有可能伴随进入培养酵解过程,导致非大肠菌群产生假阳性结果,这种情况需要对菌落进行进一步鉴定。

图1 不同的菌种在VRBA上的生长特征
VRBGA(结晶紫中性红胆盐葡萄糖琼脂)培养基的底物是葡萄糖,能支持各种肠杆菌科成员的普遍生长,典型肠杆菌科在VRBGA上呈现红色菌落,带胆盐沉淀环(如图2),但不能用来鉴别能酵解乳糖的菌属和不能酵解乳糖的菌属(如沙门氏)。

图1 不同的菌种在VRBGA上的生长特征
基于上面的区别和讨论,实验人员在使用这两款培养基时,要加以区别,避免混淆。另外,大肠埃希氏菌E.coli是大肠菌群的代表菌属,通常简称为大肠杆菌,还有些人对大肠杆菌、大肠菌群和粪大肠菌群这几个概念也容易混淆。
相关知识可参考:大肠杆菌、大肠菌群、粪大肠菌群的定义与区分 点击查看
相关产品:
结晶紫中性红胆盐葡萄糖琼脂(VRBGA)(GB4789.41-2016)-点击查看产品详情
注:本文属海博生物原创,未经允许不得转载。
| 相关文章: | ||



